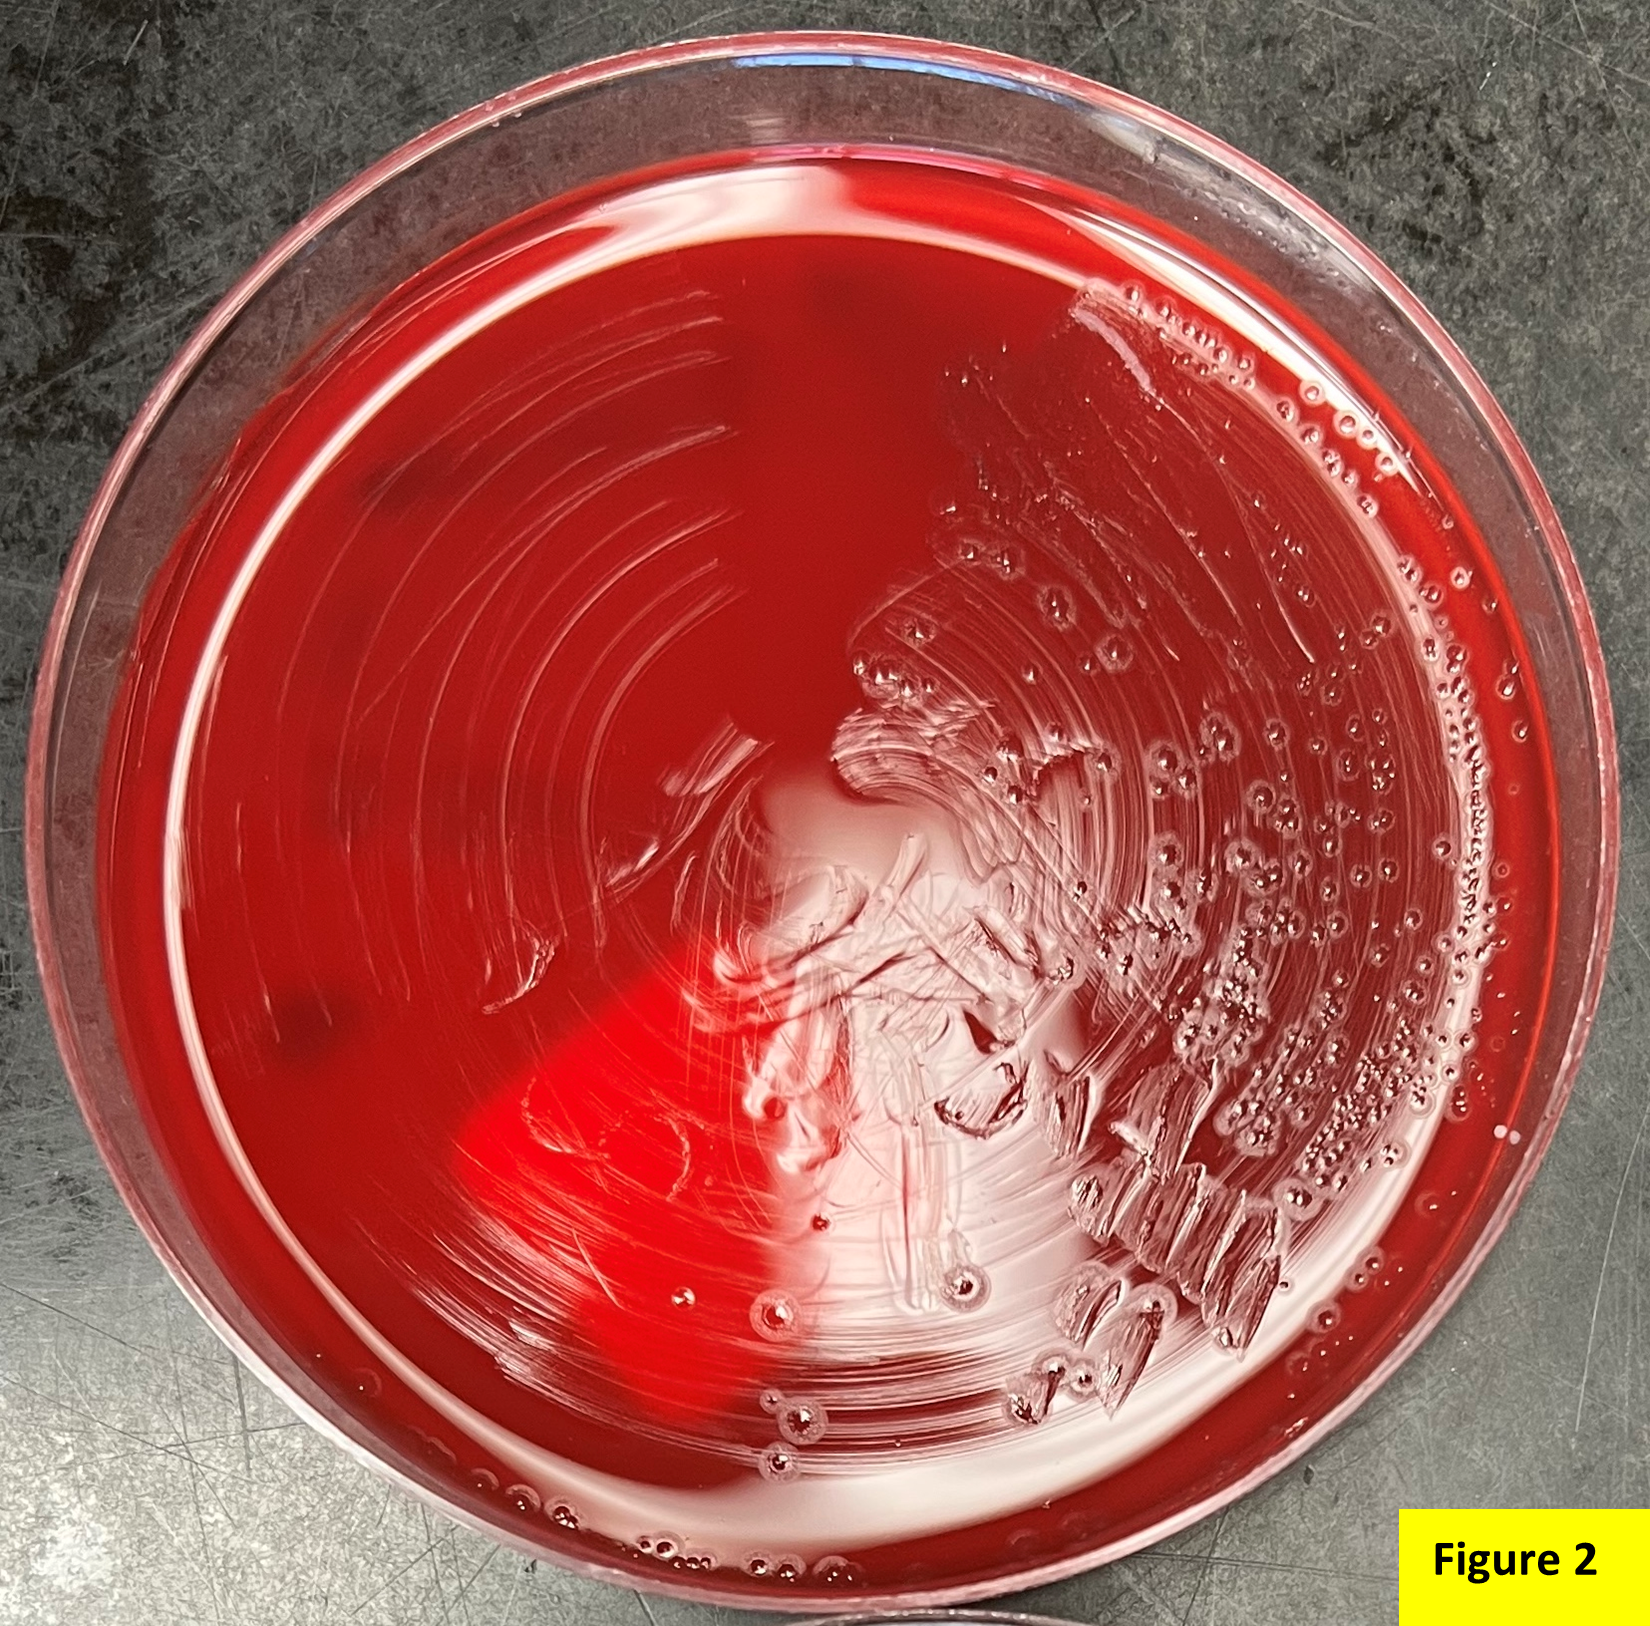

Case History
A 13 year old female presented to the emergency department with a painful left thumb swelling. Eight days ago, she picked out a hangnail from the medial side of her left thumb, resulting in a worsening pain and swelling. She went to urgent care five days ago and was prescribed Augmentin with no improvement. Physical examination showed a tender circumferential swelling of the right thumb past the flexion joint, with paronychia extending 1 cm in length with fluctuance extending an additional 0.5 cm. The wound was incised, and the drainage was sent to the microbiology laboratory for culture.
The culture grew Gram negative bacilli after 24 hours of incubation (Figure 1). The culture grew a moderate quantity of small nonhemolytic colonies that showed “pitting” appearance on blood (Figure 2) and chocolate (Figure 3) agar plates. The colonies notably smelled musty/bleachy. There was no growth on MacConkey agar.

Identification by Matrix-Assisted Laser Desorption Ionization – Time of Flight (MALDI-ToF) revealed Eikenella corrodens.
Discussion
Eikenella corrodens is a facultatively anaerobic, gram negative, oxidase positive, catalase negative, nonmotile, non-spore-forming, rod. It belongs to the HACEK group and is in the family Neisseriaceae. It is a part of the normal flora of the mouth and upper respiratory tract.
E. corrodens is an opportunistic pathogen that can lead to various infections including a variety of head and neck infections (ocular, mastoid, submandibular, thyroid), pleuropulmonary infections, skin and soft tissue infections, etc.). It can cause subcutaneous abscesses, cellulitis of soft tissues, and bacteremia in intravenous drugs users. E. corrodens also causes infections of the hand (i.e., ostomyelitis, cellulitis) because of chronic nail biting, human bite, or clenched-fist injury. The bacterium can gain access to the central nervous system by way of periodontal, middle ear, or sinus infections and cause meningitis, brain or spinal abscesses, subdural empyema, and osteomyelitis. In some predisposed individuals, endocarditis and bacteremia can also occur.
Under aerobic conditions, it grows slowly in blood and chocolate agar at 35–37℃ and does not grow on MacConkey Agar. It forms small, convex, round or irregular, gray, and non-hemolytic colonies. Most isolates may “pit” the agar although both pitting and non-pitting strains have similar biochemical characteristics. Most strains produce a musty or bleach-like odor.
E. corrodens is generally sensitive to ampicillin, amoxicillin, second- and third generation cephalosporins, tetracyclines, azithromycin, sulfamethoxazole, and fluoroquinolones. They are resistant to clindamycin, vancomycin, erythromycin, metronidazole, aminoglycosides, and penicillinase-resistant penicillins, with penicillin susceptibility varying from strain to strain. In clinical microbiology laboratories, the routine antimicrobial susceptibility testing for E. corrodens is not usually performed since it is generally responsive to beta-lactams. If necessary, susceptibility testing can be performed following the CLSI guidelines for fastidious organisms.
The disease spectrum of E. corrodens is increasing in complexity, and it is important to study its clinical characteristics for timely diagnosis, and effective treatment.
References
- Chapter 9, Color Atlas and Textbook of Diagnostic Microbiology, Seventh Edition.
- Li, L, Shi, Y-B, Weng, X-B. Eikenella corrodens infections in human: Reports of six cases and review of literatures. J Clin Lab Anal. 2022; 36:e24230. doi:10.1002/jcla.24230
- Mühlhauser M. Eikenella corrodens. Rev Chilena Infectol. 2013. doi:10.4067/S0716-10182013000200007

-Fahad Sheikh is a 2nd year AP/CP pathology resident in the Department of Pathology at Montefiore Medical Center in Bronx, NY.

-Phyu Thwe, Ph.D, D(ABMM), MLS(ASCP)CM is Associate Director of Infectious Disease Testing Laboratory at Montefiore Medical Center, Bronx, NY. She completed her medical and public health microbiology fellowship in University of Texas Medical Branch (UTMB), Galveston, TX. Her interests includes appropriate test utilization, diagnostic stewardship, development of molecular infectious disease testing, and extrapulmonary tuberculosis.